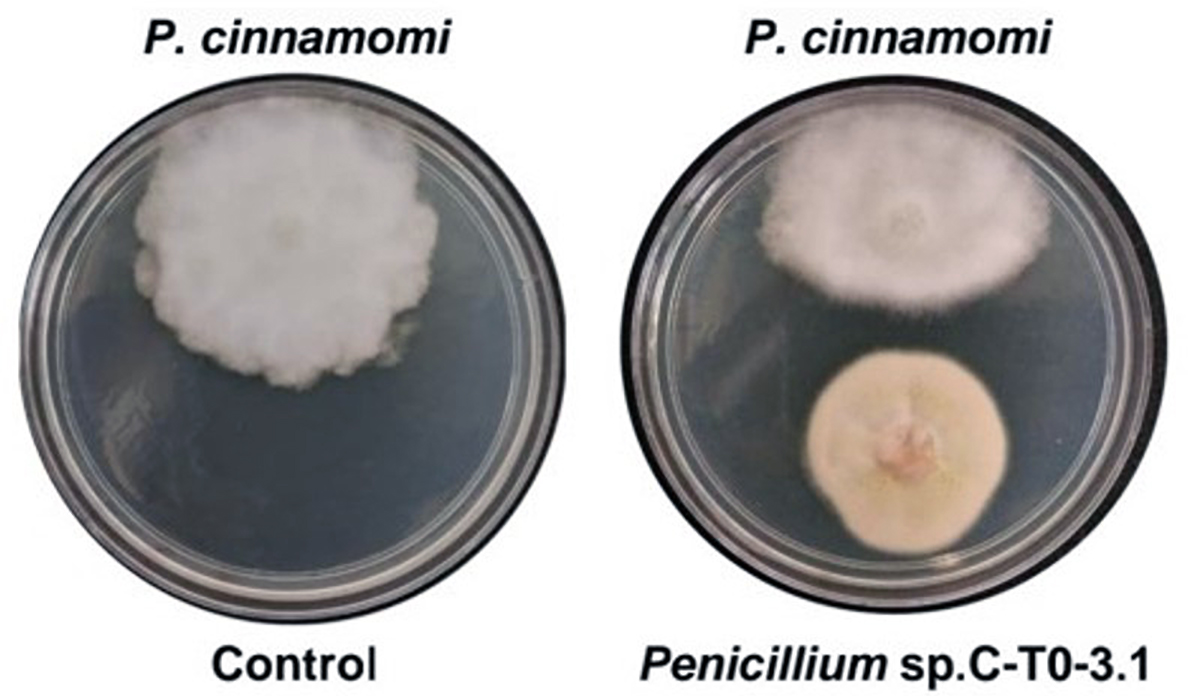

Patobioma: aliados o enemigos del patógeno
Rosaura Alfaro García1, Frédérique Reverchon1, Alfonso Méndez Bravo2

Los microorganismos que causan enfermedades pueden tener aliados o enemigos entre los microorganismos con quienes habitan en el entorno de las raíces de las plantas (la rizósfera).
Entonces, ¿Cómo saber quién es quién? Cuando pensamos en alguna enfermedad, inmediatamente imaginamos el nombre del patógeno que lo esté causando: COVID-19 = virus SARS-CoV-2, salmonelosis = la bacteria Salmonella, etc. En general, el pensamiento “una enfermedad = un patógeno” es suficiente para explicar los síntomas de ciertas enfermedades. Sin embargo, este pensamiento puede ser reduccionista y requerimos una visión más integral de la enfermedad. Por ejemplo, si tomas un antibiótico por una faringitis, esto puede debilitar tu microbiota intestinal, haciéndote más propenso a un padecimiento gastrointestinal. En este caso, los dolores de estómago serían el resultado de una alteración en tu microbioma (el conjunto de microorganismos presentes de manera natural en tu cuerpo) y se deben curar estos dolores tomando en cuenta la faringitis inicial y el antibiótico que estás tomando. Esta visión más integral de las enfermedades da origen al concepto de “patobioma”, que se comenzó a utilizar en estudios de enfermedades en humanos, pero ahora se aplica para enfermedades en otros animales y hasta en plantas. Para explicar de manera más clara lo que es el patobioma, y en qué nos puede ser útil este concepto, usaremos a las plantas como ejemplo.

Un patógeno interactuando en el barrio (rizósfera) con hongos y bacterias. Ilustración elaborada en BioRender
Piensa en el suelo que rodea las raíces de las plantas como un barrio, conocido como la rizósfera. En la rizósfera habitan microorganismos, principalmente hongos y bacterias, que ayudan a las plantas a crecer y mantenerse saludables. Sin embargo, en este mismo barrio podemos encontrar microorganismos que son dañinos para las plantas y las pueden enfermar: los patógenos. Estos patógenos viven en el barrio sin causar estragos, hasta que encuentran las condiciones propicias para desarrollarse y comenzar a enfermar las plantas. Imagina un patógeno que empieza a proliferar y a invadir el barrio. Durante este proceso, el patógeno va a interactuar con sus vecinos de la rizósfera (es decir los demás microorganismos) y los va a afectar: puede competir con ellos por comida o espacio, o producir sustancias tóxicas para sus vecinos (toxinas y antibióticos), perjudicando así su crecimiento. Al contrario, puede también llevarse bien con otros vecinos y facilitar su crecimiento, propiciando su proliferación en la rizósfera. Este patógeno modifica las relaciones dentro del barrio; decimos que el patógeno altera el microbioma de la rizósfera. Este microbioma modificado por el patógeno se conoce como “patobioma”. En el patobioma, todos aquellos microorganismos que interactúan con el patógeno de manera positiva son considerados como “aliados” en el proceso de infección. Piensa en los vecinos que se aliaron con el patógeno; si estos vecinos son patógenos también, contribuirán a enfermar la planta. Pero si interactúan de manera negativa con el patógeno, actuando como sus “enemigos”, podrían ayudan a contrarrestar su crecimiento y los síntomas que causa (Figura 1).

Fig. 1: Esquema representando la modificación del microbioma de la rizósfera por un patógeno, y la aparición de un patobioma. Estudiar a este patobioma para identificar los aliados y enemigos del patógeno nos podría ayudar a diseñar estrategias de manejo agrícola más sustentables. Elaborado en BioRender.
Pero ¿cómo podemos conocer el patobioma de un patógeno? Primero tenemos que identificar a los integrantes microbianos de la rizósfera mediante su ADN. Después, con el uso de herramientas estadísticas, podemos predecir quiénes, de entre todos los integrantes del microbioma de la rizósfera, son aquellos enemigos o aliados del patógeno, identificando los microorganismos que favorecen su presencia o, al contrario, que lo perjudican. Finalmente, podemos confirmar estas predicciones con pruebas en el laboratorio o en invernadero, para determinar cómo interactúan el patógeno y los demás “vecinos”, en cajas de Petri por ejemplo. ¿Se inhiben? O ¿se ayudan a crecer mutuamente?
Entender el patobioma de una enfermedad es crucial para un mejor manejo de las enfermedades en cultivos a nivel local y mundial. Los microorganismos que son enemigos del patógeno han tomado relevancia en la agroecología, ya que podrían utilizarse como organismos de control biológico, para frenar el crecimiento del patógeno y los síntomas que causa. Tomemos un ejemplo. En nuestro grupo de trabajo, hemos estudiado el patobioma de Phytophthora cinnamomi, uno de los principales patógenos del aguacate que causa una enfermedad llamada “tristeza del aguacatero”. En este patobioma, hemos identificado como enemigo a Penicillium sp., un hongo reconocido por la gran variedad de antibióticos que produce. Pensamos que su presencia en la rizosfera del aguacate podría ayudar a controlar el crecimiento del patógeno. Confrontando este hongo con el patógeno Phytophthora cinnamomi en condiciones de laboratorio, observamos que podía reducir su crecimiento en más de un 30% (Figura 2). ¡Sin agroquímicos! La búsqueda de microorganismos enemigos de los patógenos de las plantas estudiando sus patobiomas representa una opción alentadora para reducir la contaminación del ambiente ocasionado por el uso de pesticidas en los cultivos… ¡Es momento de cambiar el chip!
Fig. 2: Antagonismo del patógeno Phytophthora cinnamomi por Penicillium sp. En el panel de la izquierda se ve el crecimiento normal del patógeno después de siete días, en el panel de la derecha la reducción de su crecimiento por el hongo Penicillium sp. Fotografía: Emma Nieves y Frédérique Reverchon.
1Red de Diversidad Biológica del Occidente Mexicano, Centro Regional del Bajío, Instituto de Ecología, A.C., Pátzcuaro, Michoacán
2CONAHCYT, Laboratorio Nacional de Análisis y Síntesis Ecológica, Escuela Nacional de Estudios Superiores, Unidad Morelia, Universidad Nacional Autónoma de México, Morelia, Michoacán